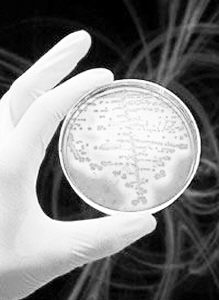

页次:1/373页 共7451篇 20篇/页 |
|||||||||||||||||||||||||||||||||||||||||||||||||||
 | |
浏览工具:    返回上一页 发布人:patent
我要发布信息 返回上一页 发布人:patent
我要发布信息 | |
| 俄科学家发现磁性细菌 内部含有钴和铬离子(图) | 2004/07/06 |
| |
| 本报莫斯科7月5日电(记者董映璧) 俄罗斯科学院生物化学与微生物学研究所经过多年研究发现,某些细菌能在自己内部形成含有钴和铬离子的磁性物质,这些内部物质的磁性只起一种辅助作用,可保护细菌,防止其金属溶液中毒。 实际上,科学研究早已证明,许多细菌具有从周围环境中吸附金属离子的性能,比如,人们发现的内含铁离子的细菌,但能使金属离子结构化形成磁性的细菌却很少见,现在俄科研人员则在特定的介质中培养出了内部含有钴和铬离子的细菌。据报道,在电子显微镜下观察这些细菌发现,这些细菌的细胞质内形成了大小从20纳米到250纳米之间的含有钴和铬离子的球形物质。同时,这些磁性物质还能够在外部磁场中移动:当把含有这些悬浮物的试管靠近磁铁时,这些悬浮物将向试管壁靠近。如果将磁铁沿试管壁移动,悬浮物也将沿磁铁移动。 科研人员认为,含有铁离子的细菌完成着重要的生理功能,它能促使无氧细菌向周围的磁铁移动,并在移动过程中使细菌进入到对于自己有利的无氧区域。在这里,某些细菌可能利用这里的化合物作为培养基,但钴和铬在外界环境中遇到的比铁少,钴和铬离子的磁性不是这些细菌的主要生理特性,只起一种次要作用,它的功能是保护细菌,以及防止无氧细胞被氧化。(科技日报) | |
 新闻博览
新闻博览 

